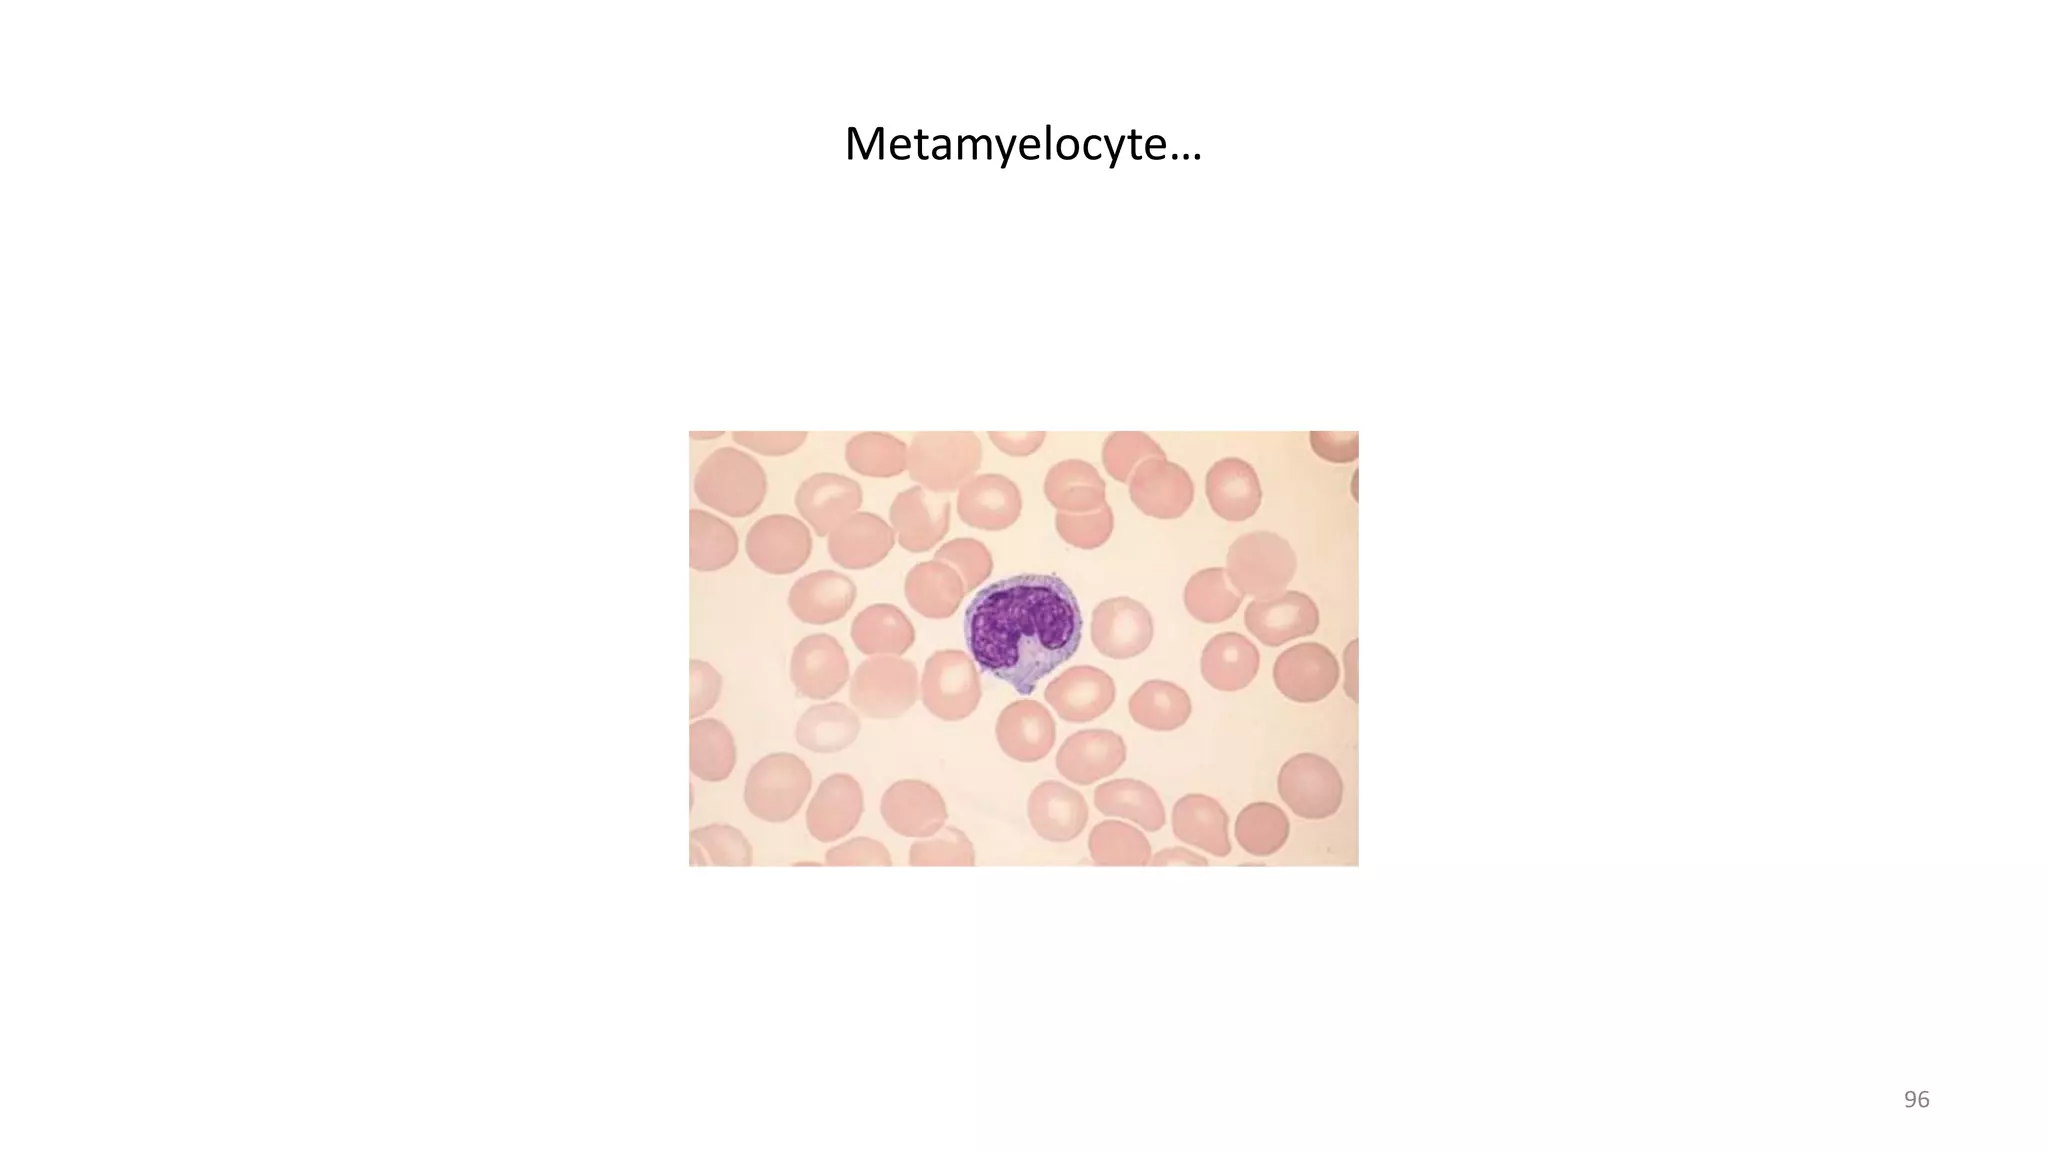
Metamyelocyte…
96
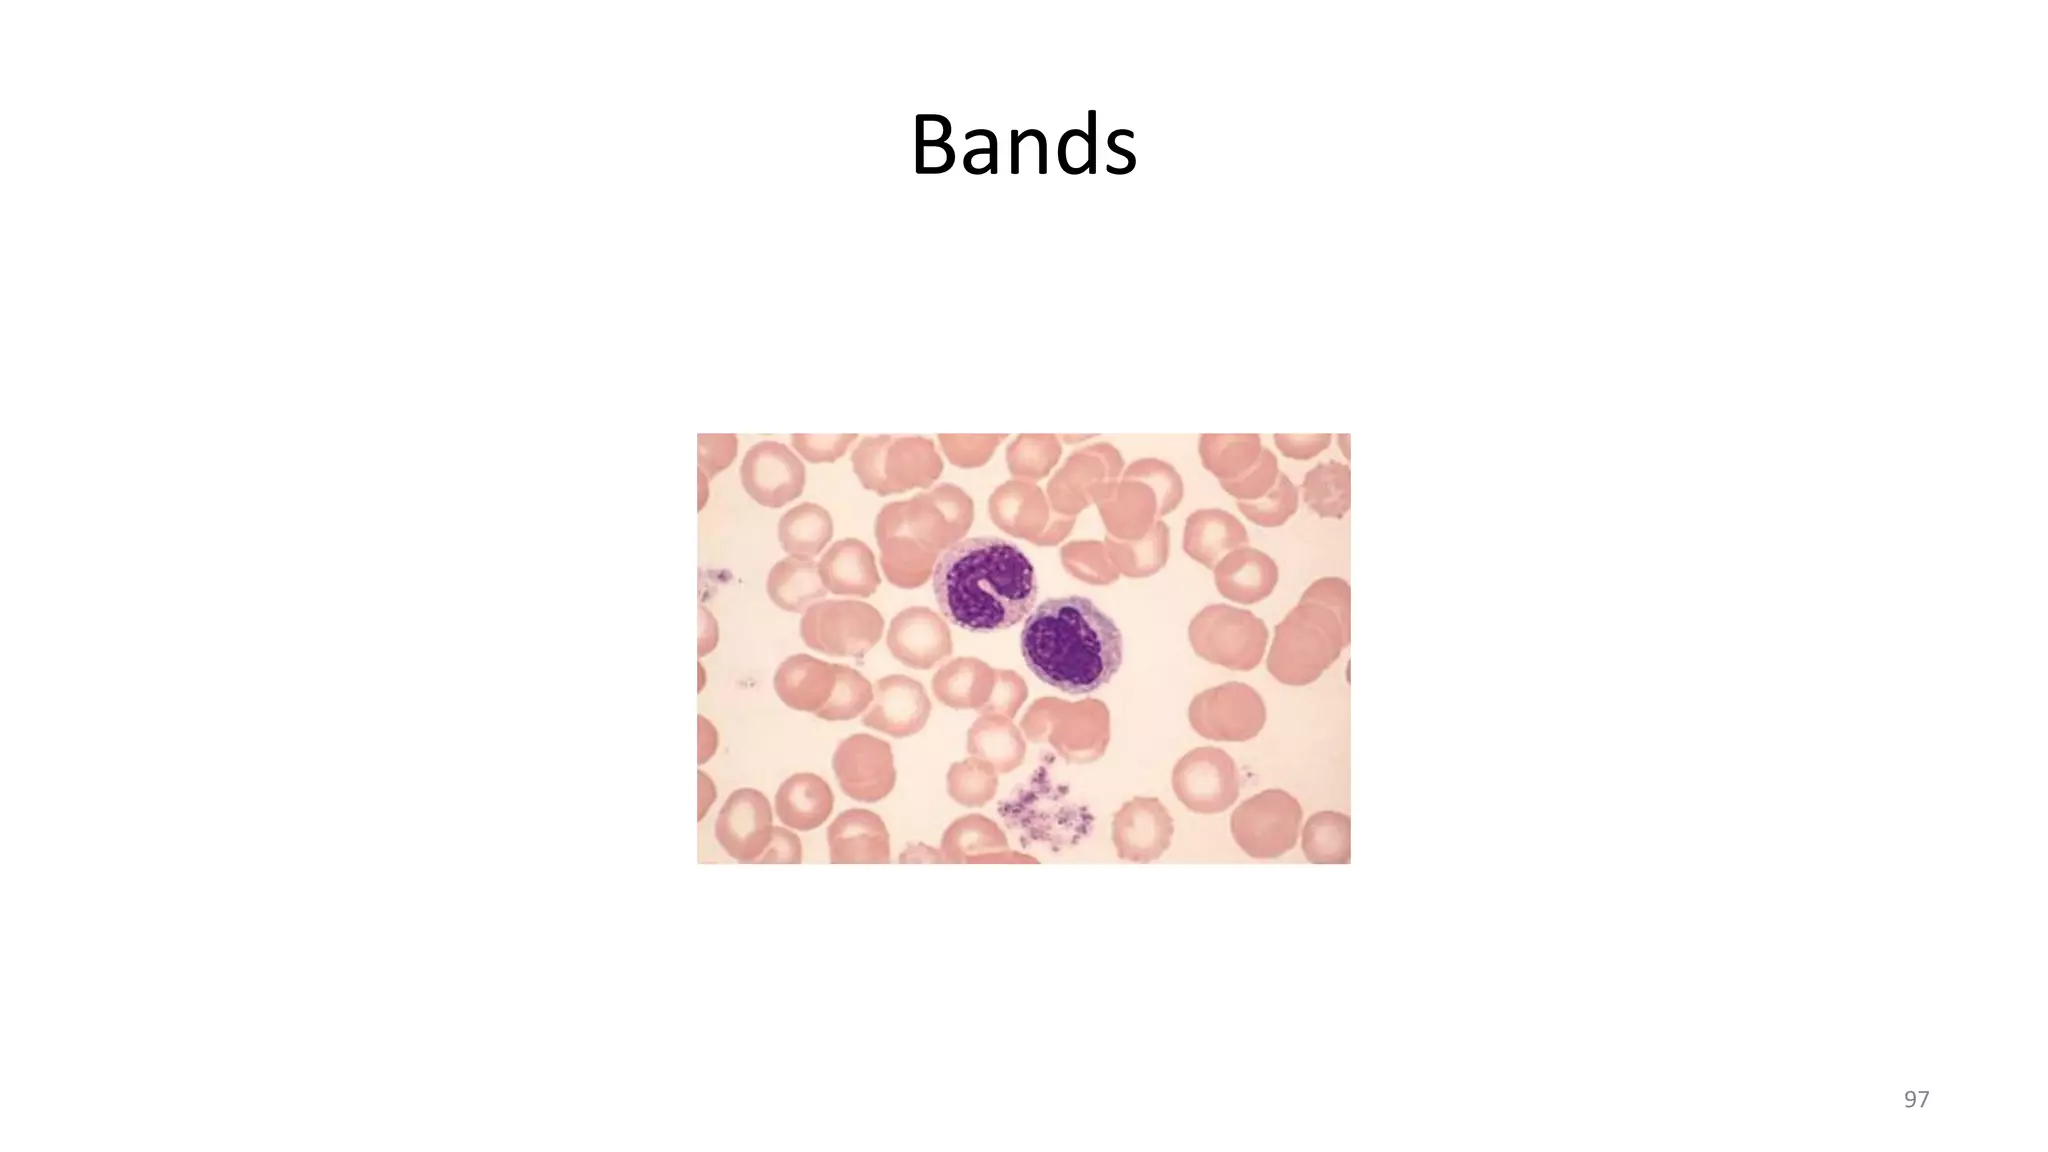
Bands
97
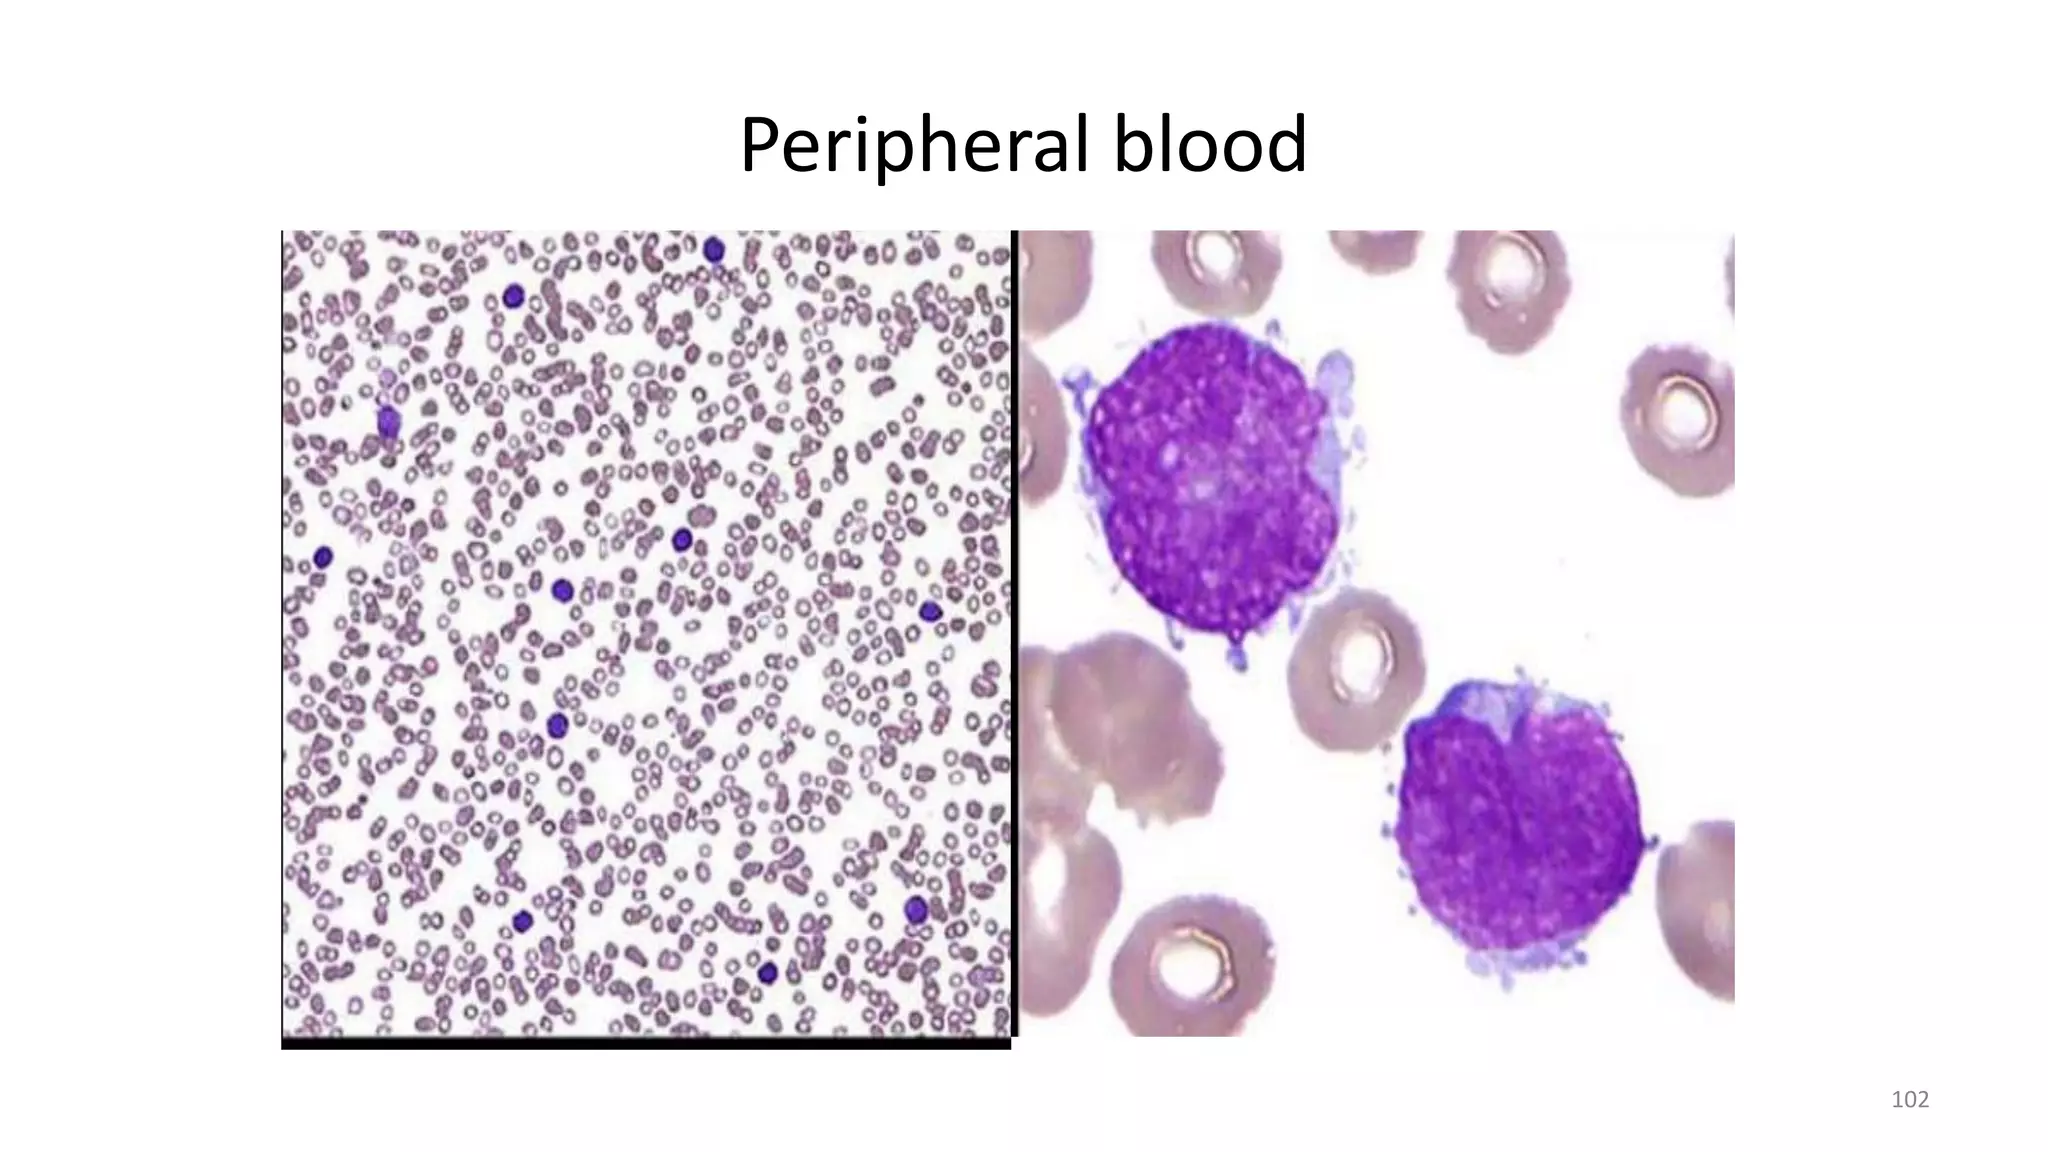
Peripheral blood
102
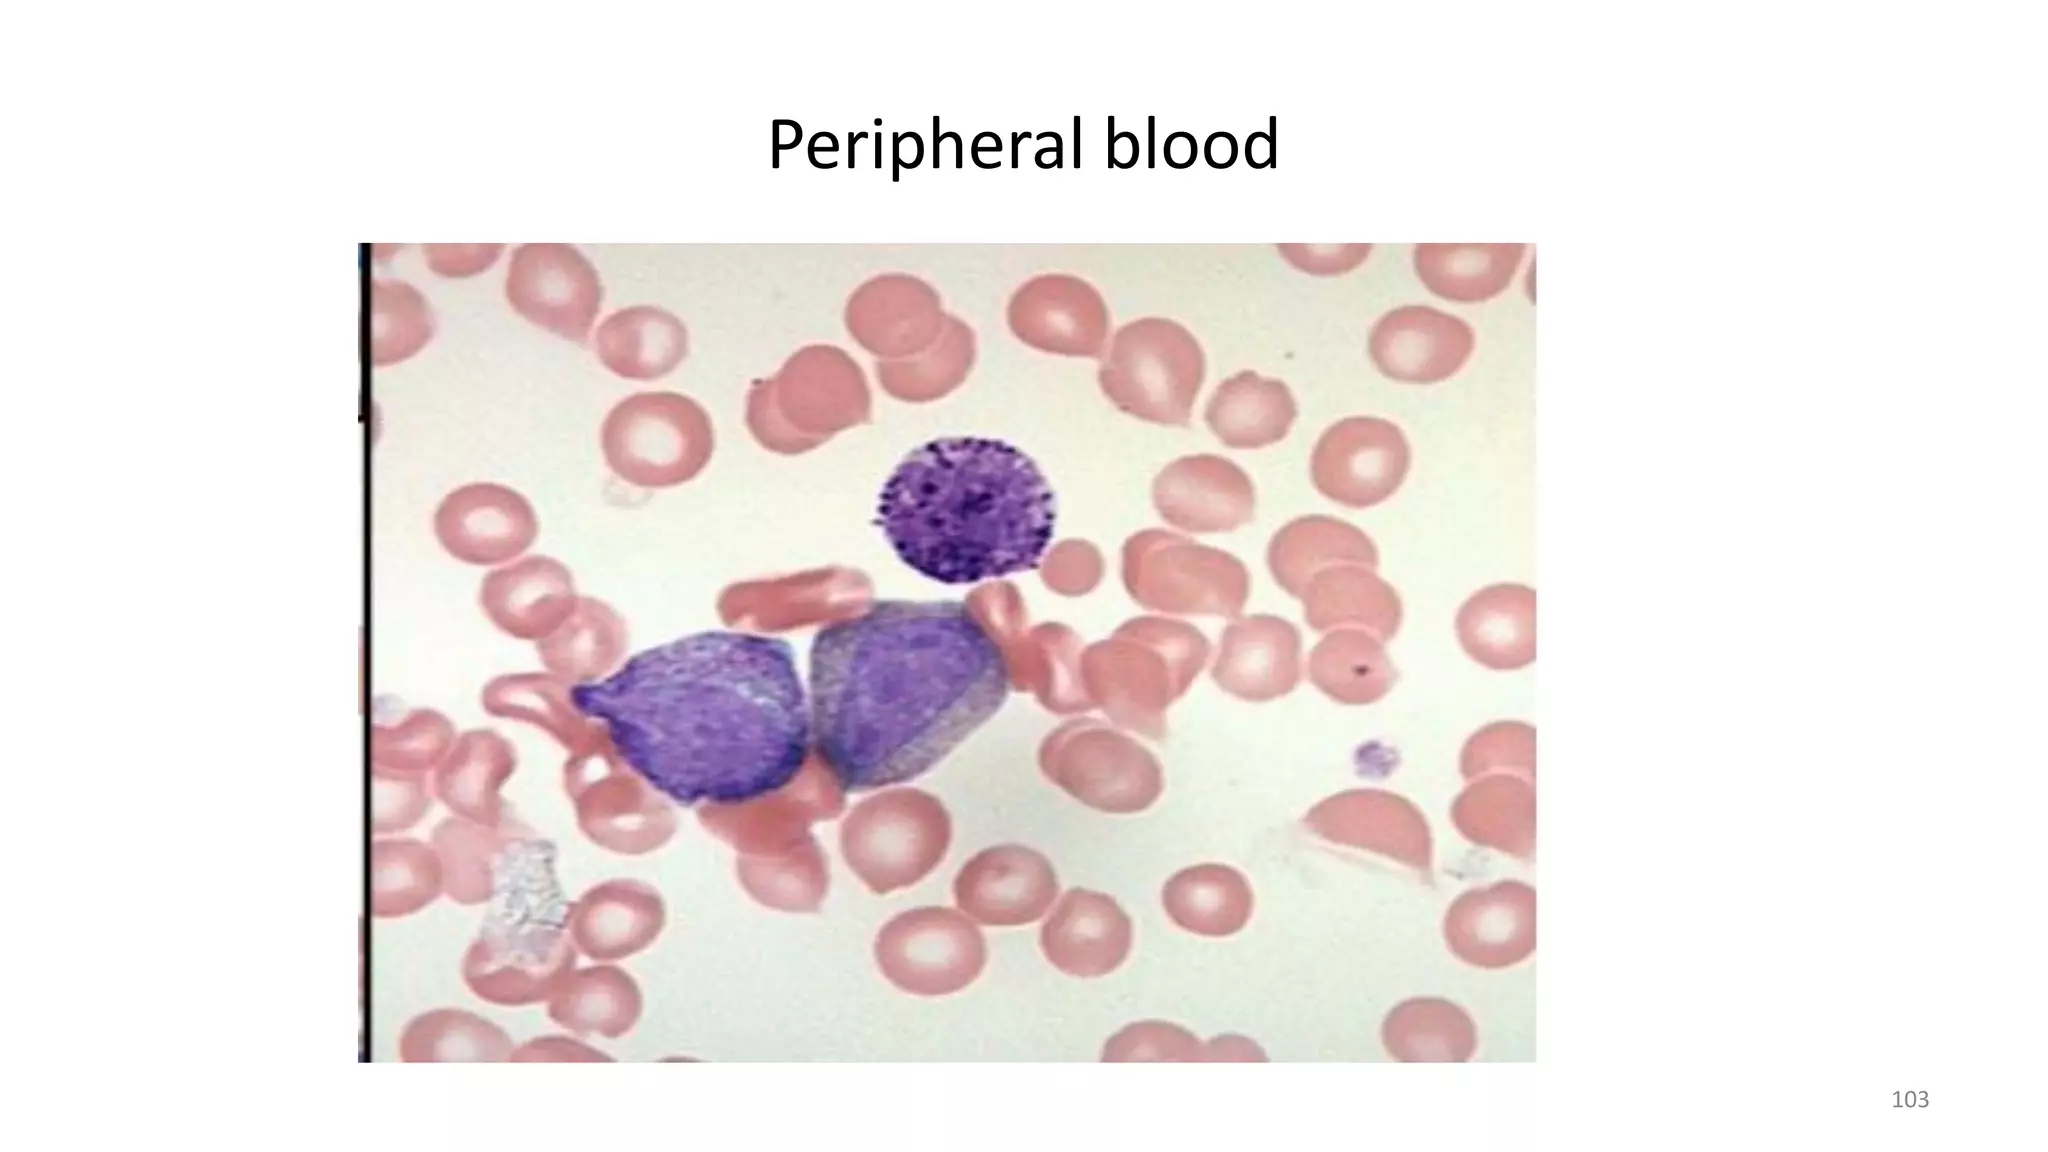
Peripheral blood
103

This document provides an introduction to the pathology department at a hospital. It includes information about the staff, facilities, and diagnostic techniques used. The main techniques discussed are cytopathology including fine needle aspiration, exfoliative cytology of body fluids, and abrasive cytology including pap smears. Histopathology is also summarized, outlining the process from biopsy to microscopic examination of stained tissue sections. Key aspects of diseases studied in pathology like etiology, pathogenesis, morphologic changes, and clinical significance are defined.